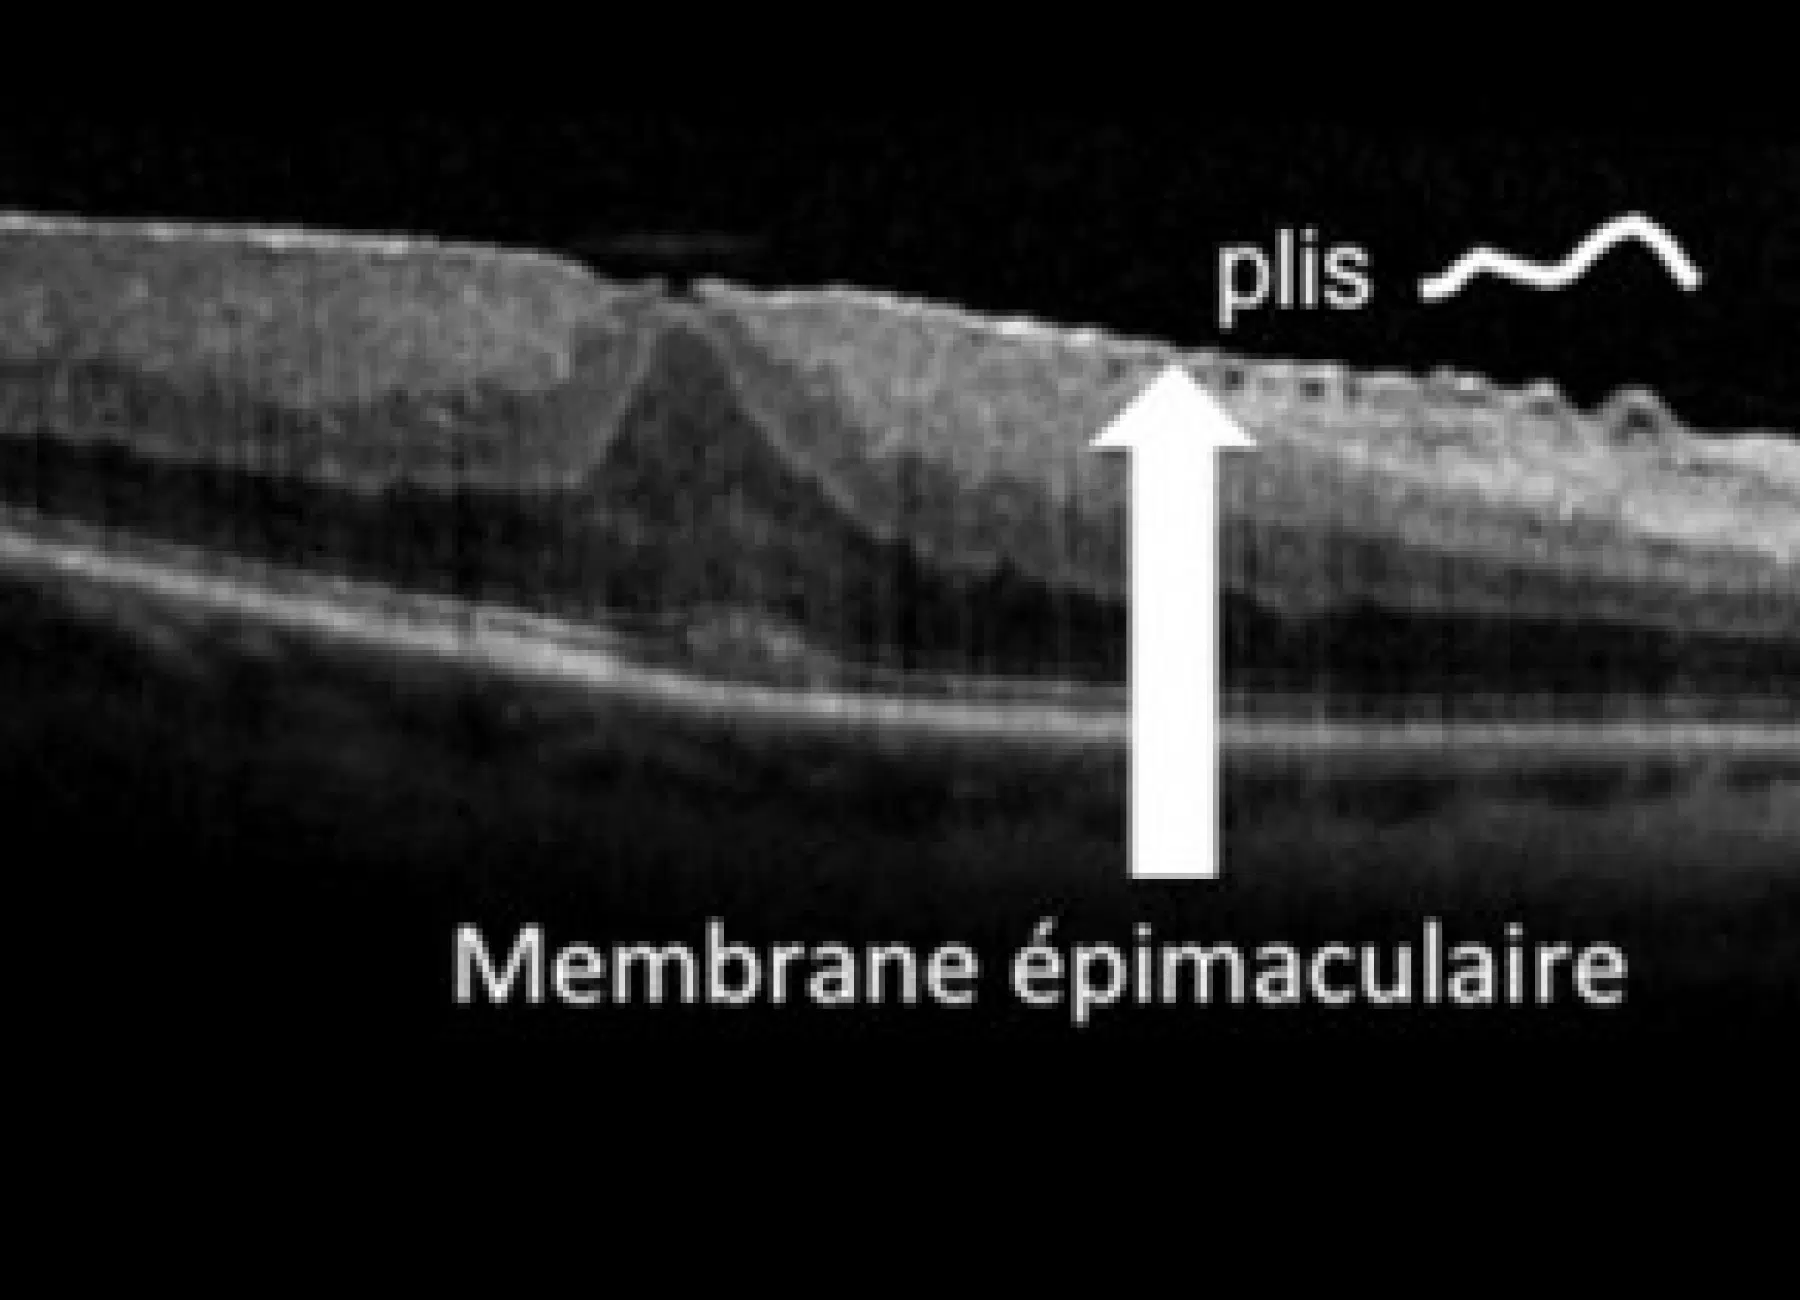

Il s’agit d’une membrane fibreuse fine se développant sur la surface rétinienne, localisée le plus souvent au niveau de la macula. En tirant sur les tissus, elle déforme progressivement cette région clé de l’œil. La vision centrale est alors impactée, notamment pour la lecture ou les activités précises. Un suivi ophtalmologique est nécessaire pour en surveiller l’évolution.
Membrane Épirétinienne MER
La Membrane Épirétinienne est une pathologie affectant la rétine, principalement la macula, zone responsable de la vision centrale. Elle entraîne des altérations progressives de la vue, avec déformations et perte de netteté. Cette pathologie, souvent bénigne, nécessite un suivi spécialisé pour limiter les répercussions fonctionnelles.
Qu’est-ce que la Membrane Épirétinienne ?
Quels sont les symptômes d’une Membrane Épirétinienne ?
Les signes varient selon l’évolution de la maladie :
- Distorsions visuelles (lignes ondulées, objets déformés)
- Vision brouillée et perte progressive d’acuité visuelle
- Perception des objets plus gros (macropsie)
- Parfois, diplopie (vision double)
Ces troubles peuvent compromettre la qualité de vie et nécessitent une évaluation rapide.
Comment diagnostiquer une Membrane Épirétinienne ?
Au Pôle Ophtalmologique Issy-les-Moulineaux, le diagnostic des membranes épirétiniennes repose sur deux étapes complémentaires : un examen clinique du fond d’œil, pour détecter les signes visibles sur la surface de la rétine, suivi d’un bilan OCT, qui offre une image en coupe ultra‑précise de la membrane, évalue son impact sur la macula et permet de constater d’éventuelles déformations rétiniennes.
Ces outils permettent une évaluation rigoureuse, essentielle pour une prise en charge adaptée.
Quand faut-il opérer une Membrane Épimaculaire ?
Une intervention chirurgicale est envisagée si :
- La vision floue gêne les tâches quotidiennes.
- Les métamorphopsies deviennent invalidantes.
La vitrectomie permet de retirer la membrane et d’améliorer la perception visuelle.
Comment se déroule la chirurgie de la Membrane Épirétinienne ?
Cette chirurgie ambulatoire comprend :
- Ablation du vitré
- Pelage de la membrane avec des outils de microchirurgie
- Injection de gaz ou solution saline pour soutenir la rétine
L’intervention dure environ 45 minutes à 1 heure.
Les résultats après une vitrectomie
Après la chirurgie d’une membrane épirétinienne, la récupération se fait étape par étape. La cicatrisation se déroule rapidement, aidée par l’administration de collyres antiseptiques et anti-inflammatoires. Dans les semaines qui suivent, les métamorphopsies diminuent sensiblement et la vision centrale devient plus claire. Bien que la récupération complète de l’acuité ne soit pas systématique, une amélioration nette de la vision est généralement constatée, avec un impact positif sur le confort de vie.
La stabilisation de la fonction visuelle peut prendre plusieurs mois, mais les résultats sont en général durables et stables dans le temps.
Si vous présentez des signes de gêne visuelle, pensez à consulter les experts du Pôle Ophtalmologique Issy-les-Moulineaux pour un diagnostic précis et une prise en charge adaptée.
